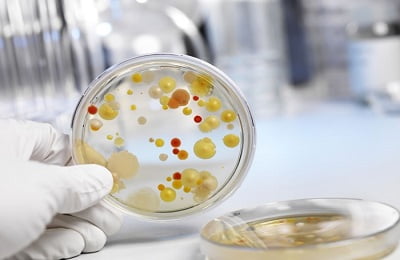
Бакпосев мокроты

Как правило, постановка диагноза начинается с того, что больной приходит к врачу с общим списком жалоб, характерных для многих недугов, – кашель, головные боли, слабость, возможно, повышенная температура.
Такие симптомы могут свидетельствовать о различных заболеваниях – от банальной простуды до туберкулеза – и только дифференциальная диагностика пневмонии при использовании современных методов исследования поможет выявить пневмонию и установить, какова ее причина.
Общий план диагностики
Когда к врачу приходит пациент с жалобами на проблемы с органами дыхания, следует определить общее направление диагностики. Для этого существует простой тест.
В нем четыре признака – наличие двух из них одновременно помогает сразу заподозрить пневмонию:
- кашель с выделением гнойной мокроты;
- повышенная температура с первого дня течения заболевания – от 38 градусов;
- одышка и затрудненное дыхание;
- повышенная концентрация лейкоцитов.
В целом же диагностика воспаления легких происходит последовательно:
- Беседа с врачом. На этом этапе происходит сбор анамнеза – врач спрашивает о жалобах, о том, были ли перенесены недавно заболевания дыхательных путей, не было ли переохлаждений.
- Осмотр грудной клетки. На этом этапе пациент должен раздеться по пояс, и врач проведет простой тест – посмотрит, не западают ли межреберные промежутки, не отстает ли одна сторона в дыхании от другой.
- Перкуссия. На этом этапе врач кончиками пальцев простукивает грудную клетку, на основе полученного звука делая вывод о состоянии легких. Если звук звонкий, как при постукивании по стенке пустой коробочки, – это свидетельствует о здоровье. Если звук глухой и спертый, – это значит, что внутри легкого растет соединительная ткань, не позволяя воздуху свободно циркулировать.
- Аускультация. На этом этапе, пользуясь стетофонендоскопом, врач прослушивает легкие. Если звук чистый, дыхание спокойное и размеренное, это свидетельствует о здоровье. Если же дыхание затрудненное, со всхлипами, хрипами и бульканьем – это признак того, что в легких скопился экссудат, мешающий их нормальной работе.
-
Лабораторные исследования. На этом этапе врач выписывает пациенту направления на показанные при подозрении на пневмонию анализы. Среди них:
- общий анализ крови, который при воспалении легких покажет завышенный уровень лейкоцитов – то есть, защитных белых телец;
- общий анализ мочи, который при наличии недуга покажет, если воспаление распространяется на почки;
- анализ мокроты, который выявит, какой из патогенных микроорганизмов спровоцировал начало болезни – от этого зависит способ лечения;
-
Инструментальные исследования. На этом этапе врач отправляет пациента на определенные обследования, которые помогут точно установить, что за процесс идет в легких. Это может быть:
- рентгенодиагностика, которая покажет расположение очагов заболевания, их распространенность и сопутствующие осложнения;
- томография выявит наличие опухолей или деформаций – назначается при осложнениях;
- УЗИ покажет наличие экссудата внутри легких и его расположение – также назначается при осложнениях;
- бронхоскопия, при которой пациенту в легкие введут специальный длинный шланг с лампочкой на конце – этот тест позволяет фактически заглянуть в легкие и применяется только при осложненном лечении заболевания.
По итогам всех основных исследований (а при необходимости и дополнительных, таких, как УЗИ и томография), врач сможет точно поставить диагноз и назначить адекватное лечение.
к оглавлению ↑
Перкуссия и аускультация
Эти два способа – простукивание и прослушивание – основные методы при диагностике пневмонии у детей. Рентгенодиагностика – основной метод для взрослых, из-за опасности малышам назначается только в критических случаях, когда никакой другой тест нужный результат не даст.
С помощью перкуссии определяют:
- Где расположены очаги заражения – в этих местах грудная клетка отзывается другим звуком, по сравнению со здоровыми участками органа;
- Насколько легкие наполнены воздухом – звук при пневмонии отличается от такового у человека со здоровыми легкими.
По-настоящему поставить диагноз таким способом могут только опытные врачи, которые точно уверены в особенностях патогенных звуков.
С помощью аускультации и у взрослых, и у детей определяют:
- Наличие разрастающейся соединительной ткани – если присутствует данное явление, некоторые участки легких не будут прослушиваться.
-
Наличие бронхита – если он есть, в легких будут слышны сухие, распространенные хрипы;
Бронхит
- Наличие в легких экссудата – если он в них есть, звук будет «хлюпающим» и таким, как будто в легких надуваются и лопаются маленькие пузырьки (чтобы уточнить его количество и расположение впоследствии нужно использовать УЗИ);
Если у человека классическая пневмония, захватывающая легкие полностью и хорошо видная как на УЗИ, так и при томографии, симптомы будут четко выраженными и очевидными. Однако если у больного очаговая пневмония и поражены только отдельные участки, всегда есть шанс их пропустить, особенно если они неудачно расположены.
к оглавлению ↑
Лабораторные исследования
Основным исследованием при пневмонии является бактериологический тест. Суть этого метода заключается в следующем:
- стерильной палочкой из верхних дыхательных путей у пациента берут мазок;
- на анализ также берется небольшое количество мокроты;
- полученные объекты исследования помещают в разные питательные среды;
- бактерия-возбудитель начинает размножаться в наилучшей для нее питательной среде.
В результате данного теста моно выявить, какой именно микроорганизм стал причиной пневмонии. При этом если:
- у пациента классическая пневмония, тест используется только для определения возбудителя – заболевание протекает слишком быстро, чтобы из теста можно было извлечь иную пользу;
- у пациента длительная атипичная пневмония, посев проверяют на чувствительность к антибиотикам, чтобы подобрать лекарство направленного действия.
ВАЖНО! Несмотря на обилие диагностических мероприятий для детей и взрослых – и УЗИ, и рентген, и томография — ни одно из них не является второстепенным. Диагностируют пневмонию только на основе комплексного подхода.
к оглавлению ↑
Инструментальные исследования
В случае, когда речь идет о взрослых, рентгенодиагностика является одним из основных методов выявления пневмонии.
Читайте также:
Современные методы реабилитации при пневмонии
Она позволяет увидеть:
- воспаления, которые на снимке кажутся темнее, чем остальное легкое;
- изменение легочного рисунка, которое на снимке кажется более темным и искаженным по сравнению с нормой;
- разрастание соединительной ткани и рубцы.
На основании рентгена диагноз ставится окончательно, и если у взрослых он проводится в любом случае, то у детей – только если есть показания.
- Томография дает примерно тот же эффект, что и рентгенодиагностика, но при этом оказывает большую лучевую нагрузку на организм, потому применяют ее редко, для определения атипичных пневмоний.
- УЗИ в случае подозрения на пневмонию применяется редко – только если в легких есть экссудат, который остальные методы исследования показывают не так хорошо. Другие проявления пневмонии увидеть на УЗИ практически невозможно.
- Бронхоскопию применяют у взрослых при атипичных пневмониях, которые на рентгене практически не видны – сам по себе этот метод используется для получения более точных результатов. В случае классической пневмонии его применение неоправданно.
ВАЖНО! И рентген, и томография, и УЗИ не требуют специальной подготовки – только бронхоскопию делают натощак.
к оглавлению ↑
Как отличить воспаление легких от других легочных заболеваний?
У пневмонии существует большое количество разновидностей, при том, что симптомы ее для самого больного мало отличаются от симптомов гриппа или тяжелой простуды. Даже для взрослых пациентов практически невозможно отличить ее от чего-то более безобидного.
Только дифференциальная диагностика пневмонии (рентген, посев, при необходимости – УЗИ) позволяет отличить ее от других легочных заболеваний.
При недуге возникает такая клиническая картина:
- кашель – или с постоянным отхаркиванием мокроты, или длительный сухой;
- слабость и общее ощущение недомогания;
- головные боли, головокружение, замедленность реакций;
- повышенное содержание в крови лейкоцитов;
- определенные виды бактерий, выявляемые с помощью бактериологического посева;
- характерная картина на рентгене – участки затемнения, искаженный легочный рисунок, распространение соединительной ткани;
- характерная картина при прощупывании и простукивании – хрипы, бульканье, затрудненное дыхание.
Только на основе диагностических результатов УЗИ, рентгена, томографии, свидетельствующих о пневмонии, врач может поставить диагноз и начать лечение, которое у детей и взрослых будет разниться.
Бондаренко Татьяна
Эксперт проекта OPnevmonii.ru
Статья помогла вам?
Дайте нам об этом знать — поставьте оценку
Загрузка…
Adblock
detector
Врач-терапевт, сомнолог
Стаж 14 лет
Врач высшей категории. Член Европейского респираторного общества и Российского респираторного общества
Записаться на прием
Автор статьи: Новиков Максим Сергеевич, Врач терапевт второй категории, член European Respiratory Society
Воспаление легких считается серьезной болезнью, поскольку во многих случаях заканчивается летальным исходом. При пневмонии поднимается температура, проявляется воспалительный процесс в легких, причиной возникновения его становятся различные инфекции: пневмококки, легионелла, микроорганизмы и грибки. При воспалении легких у больных имеются специфические симптомы и болезненные ощущения в груди, заболевание требует немедленного стационарного лечения в больнице, исходя из стадии и тяжести протекания.
Общая информация о воспалении легких
Для тех, кого интересует, что это такое, в материале расскажем детально о воспалении легких, методах лечения, профилактике и прогнозах на выздоровление при правильно выбранном лечении. Подробно приведем симптомы пневмонии, по которым можно однозначно определить наличие заболевания принять своевременные меры.
Пневмония – это воспалительный процесс одного легкого или двух, который характеризуется поднятием температуры, выбросом жидкости в альвеолы. Это небольшие воздушные ячейки в легком, стенки которых отвечают за газообмен и являются составными частями легочных тканей.
Риску возникновения и развития пневмонии чаще всего подвергаются дети и люди пожилого возраста, которые имеют ослабленный иммунитет, хронические болезни, сахарный диабет, проблемы с сердечно-сосудистой системой. Также в группе риска находятся пациенты, злоупотребляющие курением и употреблением алкоголя, люди с врожденными проблемами дыхания и легочной системы.
При неграмотном или несвоевременном лечении пневмония может иметь следующие негативные последствия, как отечность легкого у взрослого человека, заражение крови. В качестве профилактических мер, позволяющих избежать воспаления легких взрослых, используется вакцинация против пневмококковой или гемофильной инфекции. Однако данные меры рекомендованы только для профилактики в больших коллективах, где высока вероятность передачи заболевания воздушно-капельным методом.
Симптомы заболевания
Пневмония имеет различные проявления и симптомы заболевания у взрослых, по которым опытный врач сразу определит стадию и особенности патологии. Рассмотрим симптомы классической пневмонии, развитие которой вызывается пневмококком:
- возрастание температуры тела до критичных 39-40 градусов;
- сильный кашель с выделением мокроты из легкого взрослого;
- болезненные ощущения в груди в процессе кашля и дыхания;
- хрипы, которые можно услышать при прослушивании легкого.
При атипичном проявлении воспаления легких, которое спровоцировано микоплазмой или хламидией, также характерны другие симптомы у взрослых:
- высокая температура, которая поднимается до отметки 40 градусов;
- сухой кашель, который вскоре превращается во влажный с отделением большого количества мокроты;
- боли в мышцах и тканях;
- постоянное першение в горле;
- общее плохое самочувствие.
Нередко замечая такие симптомы, как повышенная температура, пациенты принимают пневмонию за обычное респираторное заболевание. Но следует всегда принимать во внимание классические симптомы пневмонии, наличие их говорит о немедленной необходимости начать лечить воспаление легких в условиях стационара клиники. Окончательный диагноз воспаления легких ставит опытный врач после того, как берет лабораторные анализы и обеспечивает проведение тщательной диагностики, чтобы эффективно бороться непосредственно с причиной.
Стадии пневмонии характеризуются симптомами, которые несколько отличаются по специфике того, как они протекают у людей разного возраста, а также на основании склонности к хроническим заболеваниям. Легкая предполагает, что у пациента несколько дней повышена температура, причем у женщин и мужчин имеются аналогичные симптомы. При легкой форме у пациента наблюдается также кашель с отделением мокроты, который постоянно нарастает, причиной этому становится постоянное накопление мокроты.
Читайте также:
Пневмония как защититься от заражения
Пневмония или воспаление легких протекает при тяжелой стадии с критическим повышением максимальной температуры на протяжении длительного времени, которая не сбивается. Также характерны одышка, бледность кожного покрова, синий оттенок кожи в носогубной зоне. Данные симптомы болезни говорят о том, что пациенту требуется немедленная госпитализация в больницу.
Диагностика: процедуры и особенности проведения
Диагностика воспаления легких предполагает, что в комплексе проводятся такие процедуры:
- осмотр у врача, который выявит основные признаки, характерные для воспаления легких взрослых. Также доктор выслушивает жалобы, после чего направляет для проведения процедуры проведения лабораторных анализов и обследования с помощью современного оборудования;
- рентгенография грудной зоны, которая требуется практически во всех случаях для уточнения диагноза. При помощи рентгенографии можно четко рассмотреть очаги, выявить, какая стадия заболевания на текущий момент, установить факт частичной или обширной пневмонии;
- исследование мокроты под микроскопом при помощи метода серологической диагностики. При помощи такой методики можно установить наличие определенной инфекции в организме, которая спровоцировала воспаление легких;
- диагностика посредством взятия анализа крови информирует о числе белых кровяных телец, то есть позволяет выявить вирусную или бактериальную природу заболевания;
- бронхоскопическая диагностика – считается неприятной процедурой, однако дате возможность врачу детально изучить бронхи, выявить воспаление легких. Проведение процедурыподразумевает, что в нос или рот пациента вставляется тонкая трубка, при помощи которой можно взять анализ мокроты из легкого и бронхов. Иногда необходима пункция при воспалении легких в осложненной форме с целью удалить из легкого взрослого человека скопившуюся жидкость и мокроту.
Воспаление легких диагностируется врачом, основываясь на жалобах пациента, наличии у него затрудненного дыхания, температуры, одышки и других основных признаков.
Проведение диагностики и исследований ставит перед собой цель определить стадию и форму заболевания, среди которых основными являются:
- острая пневмония, или крупозное воспаление легких – характеризуется чрезмерным ознобом и повышением температуры до максимума 40 градусов. При одностороннем воспалении легких появляется значительная боль в боку, а при двустороннем боль может болеть вся грудная клетка и зона между лопатками. При этом наблюдаются значительные затруднения и проблемы с дыханием у взрослого, сухой кашель часто переходит в отхаркивание мокроты с кровяными сгустками;
- вялотекущая форма – наблюдается температура до 38 градусов, вялость и общее недомогание, утеря аппетита. Данная форма пневмонии у взрослых часто возникает как осложнение после перенесенной на ногах простуды или бронхита;
- затяжная форма – ее диагностируют как последствие недолеченной острой пневмонии, может наблюдаться атрофия легочного органа и нарушение доставки кислорода, если лечение не продолжить в условиях стационара.
Непосредственно от тщательной и глубокой диагностики и квалификации врача, грамотного определения причины и симптомов зависит правильность назначения терапии.
Какой врач лечит заболевание
Для пациентов, которым интересно, какой врач лечит болезнь в клинике и занимается диагностированием, ответ однозначен – лечит терапевт или пульмонолог. Легкие тщательно простукиваются, чтобы выявить признаки пневмонии, в зависимости от тяжести протекания назначается рентген или вспомогательная бронхоскопия. Врач назначает анализ и лабораторные исследования, чтобы определить наличие бактерий и вирусов определенной этиологии.
В клинике АО «Медицина», функционирующей много лет в Москве, работают врачи, которые могут четко установить диагноз, причины, симптомы заболеваний. Проводятся данные мероприятия, чтобы профессионально провести диагностику и лечение воспаления легких с благоприятным прогнозом выздоровления. Все врачи клиники имеют многолетний опыт, что позволяет провести качественное обследование и справиться с болезнью.
Доктора регулярно проходят курсы повышения квалификации, что позволяет с высокой успешностью проводить лечение пневмонии. С сертификатами, квалификациями докторов можно ознакомиться на сайте медицинского центра.
Методы лечения
Для обеспечения грамотного лечения пневмонии, подбора подходящего метода лечения, необходима предварительная консультация и обследование, проведенные терапевтом или пульмонологом. Только после того, как поставлен диагноз и определена форма заболевания, можно начинать лечение.
Методы и способы, как лечить пневмонию, определяются степенью, возрастной категорией больного и наличием показаний и осложнений. Госпитализация с пневмонией осуществляется только по рекомендации врача, если для этого выявлены веские основания и причины.
Чтобы вылечить воспаление легких у взрослых, требуется использовать в комплексе методы этиологической и симптоматической терапии. Эффективность первой группы методов лечения обусловлена уничтожением полностью всех очагов заболевания, а методы лечения второй группы нацелены на избавление от проявлений патологий, связанных с воспалением легких.
В ходе лечения пневмонии применяются антибактериальные медпрепараты, антибиотики, прочие лекарственные средства, позволяющие вылечить кашель, стабилизировать дыхание и температуру тела, избавить легкие от скопившейся мокроты. Медикаменты назначаются, исходя из стадий пневмонии, тяжести протекания. Также чтобы успешно лечить воспаление легких, не стоит забывать о физио- и магнитотерапии, упражнений из гимнастики для дыхания.
Рассмотрим детально, при помощи каких методов можно эффективно лечить пневмонию независимо от стадий.
Симптоматическое лечение пневмонии
Нацелено на улучшение общего состояния больного, снижение температуры, нормализацию дыхания вследствие борьбы с сухим кашлем. Ключевыми препаратами терапии являются средства муколитического назначения и медикаменты с жаропонижающим эффектом для активного понижения у взрослых температуры тела.
Принципы лечения подразумевают, что муколитики способствуют действенному выведению слизи из органов дыхания, также многие препараты поддерживают действие антибактериальных средств, что помогает более эффективно справиться с воспалением легких. Применяются следующие препараты, обеспечивающие лечение пневмонии:
- Карбоцистеин;
- АЦЦ;
- Амброксол и производные данных препаратов.
Необходимую дозировку назначают только врачи после проведения соответствующего обследования, также длительность приема варьируется в зависимости от того, какая стадия пневмонии у больного.
Причем отметим, что сбивание у взрослых температуры необходимо проводить только тогда, когда температура достигла отметки 39 градусов, при этом у пациента резко кардинально ухудшается самочувствие.
Антибиотикотерапия при пневмонии
Для избавления от ярко выраженных симптомов болезни, эффективной борьбы с высокой температурой, используется лечение болезни с помощью антибиотиков. Однако прежде чем назначать активные антибиотики, которые могут нанести непоправимый вред организму, врач назначает анализы и комплексное обследование. На практике выделяются отдельные категории пациентов, для которых метод борьбы с воспалением легких и применение препаратов будет существенно отличаться:
Читайте также:
Что делать с кашлем после пневмонии
- первая категория — пациенты в возрастной группе до 60 лет, у которых симптомы схожи, и лечение проводится по аналогичной схеме. У данной группы пациентов нет патологий, хронических заболеваний, пневмония протекает легко и без значительных осложнений, температура не поднимается выше отметки 38 градусов. В лечении болезни используются пенициллины и макролиды, в большинстве случаев терапия осуществляется в домашних условиях под чутким контролем врача, как происходит протекание болезни. При необходимости сбить температуру используются жаропонижающие средства орально, при затрудненном дыхании предписываются муколитики;
- вторая категория – пациенты в возрасте от 60 лет и более, которые имеют сопутствующие патологии сердечно-сосудистой системы, почек, органов дыхания. Также в данную группу включаются пациенты, имеющие проблемы с алкоголизмом, они более подвержены развитию пневмонии, данной категории рекомендовано своевременно провериться при затяжном кашле, а также если на протяжении длительного времени повышена температура тела на фоне общего недомогания. Наиболее эффективный метод лечения воспаления легких предполагает цефалоспорины третьего поколения и аминопенициллины. Пациенты данной группы всегда проходят терапию в стационаре клиники под наблюдением врачей;
- третья категория – включает людей в любом возрасте, у которых пневмония протекает крайне тяжело, при этом пациенты жалуются на нарушения дыхания, а температура долго держится на отметке 39-40 градусов. В зависимости от стадии и тяжести, пневмонией у больных этой категории занимаются доктора в реанимационном отделении при помощи наиболее эффективных и быстродействующих медикаментов.
Прогноз при заболевании пневмонией подразумевает, что при своевременном оказании медицинской помощи пациент полностью выздоравливает. Однако полностью признаки и симптомыисчезают не ранее чем через 20-30 дней. Если в дальнейшем пациент начинает болеть простудой независимо от вызвавших ее причин, необходимо принимать тщательные меры, чтобы при возникновении соответствующих симптомов не допустить повторного заболевания, которое может протекать в более жесткой форме.
Показания при заболевании
Показания докторов при состояниях, когда у пациента повышена температура, наблюдаются затруднения дыхания, предполагают следующие мероприятия:
- если пневмония в легкой стадии лечится в домашних условиях, для максимальной эффективности терапии требуется обеспечить человеку соответствующий уход с преобладанием постельного режима;
- специальная диета, в результате которой улучшаются анализы, устраняются причины сопутствующих заболеваний. Для этого необходимо убрать из рациона жирную и тяжелую пищу, отдавать предпочтение фруктово-овощной диете. Таким образом можно существенно улучшить общие показатели анализов крови;
- употребление достаточного количества жидкости для отведения мокроты. Помимо этого, таким образом снижается температура. Рекомендуется выпивать около трех литров воды, натуральных соков;
- физиотерапевтическое лечение показано в некоторых случаях, что дает возможность снизить риски осложнений после пневмонии.
Противопоказания при заболевании
Способы самолечения на любой стадии полностью противопоказаны, поскольку при неграмотном применении препаратов повышается риск осложнений, может значительно усугубиться состояние больного. Рассмотрим наиболее важные противопоказания:
- игнорирование серьезности заболевания и отсутствие лечения, что приводит к запущенной форме и осложнениям;
- чрезмерная физическая активность, перехаживание с температурой, что усугубляет течение патологического процесса. При выявлении первых признаков и симптомов необходимо снизить активность и проверить организм на наличие вирусов, болезнетворных бактерий;
- курение и алкоголизм полностью противопоказаны при пневмонии;
- переохлаждение организма и посещение бани, сауны, поскольку чрезвычайно высокая температура уже испытывает организм больного на прочность, а в бане сердечно-сосудистая система может не выдержать чрезмерной нагрузки.
Стоимость первичного приема, исследований, лечения
Клиника АО «Медицина» предлагает изначально записаться на предварительную консультацию к квалифицированному врачу терапевту или пульмонологу, который назначит требуемые исследования и определит, сдача какого анализа необходима для подтверждения первичного диагноза. Четкое диагностирование проводится только после того, как анализ поступает врачу. Стадия и форма протекания также определяется лечащим врачом, исходя из чего происходит назначение наиболее эффективного метода лечения пневмонии у взрослых.
Стоимость первичного приема у докторов клиники начинается от 4500 рублей, при этом вторичный осмотр и назначение препаратов, схемы лечения уже стоит меньше. Стоимость леченияопределяется множеством факторов, таких как сложность протекания патологии, наличие осложнений, сопутствующих патологий, которые могут провоцировать негативные прогнозы.
Цены на лечение и все процедуры указаны на сайте в прайс-листе. Сдавать анализы можно непосредственно в медицинском центре, при этом предоставляются скидки на комплекс услуг. Для корпоративных клиентов также предлагаются скидки. И еще медцентр сотрудничает со страховыми компаниями, поэтому пациенты могут полностью покрыть цены лечения в современнойклинике при помощи страховых выплат.
Преимущества лечения в клинике АО «Медицина»
Выбирая клинику АО «Медицина», пациенты получают высококлассный сервис и устранение имеющихся проблем со здоровьем. Излечение воспаления легких в клинике в Москвеосуществляется по новейшим методикам с применением наиболее эффективных препаратов. Рассмотрим основные достоинства прохождения стационарного лечения у докторов «АО «Медицина»:
- приемлемые цены, которые подразумевают высокое качество сервиса;
- клиентоориентированность, доктора стараются учитывать пожелания пациентов касательно уровня комфортности палат, питания;
- высококвалифицированные доктора, которые имеют соответствующие сертификаты, регулярно проходят курсы повышения квалификации в ведущих клиниках США и Европы, которые могут четко поставить диагноз воспаления легких у взрослого;
- использование высокотехнологичного медицинского оборудования для проведения обследований для выявления определенной стадии воспаления легких, взятия лабораторных проб;
- качественная стерилизация инструментов, использование одноразовых расходных материалов;
- использование современных стандартов лечения при воспалении легких, чтобы обеспечить полноценное излечивание без осложнений и остаточных явлений.
Учитывая множество преимуществ, в медицинском центре предлагаются конкурентоспособные цены на квалифицированное лечение. Для записи на первичный осмотр и консультацию можно оставить заявку на сайте или связаться по телефону.